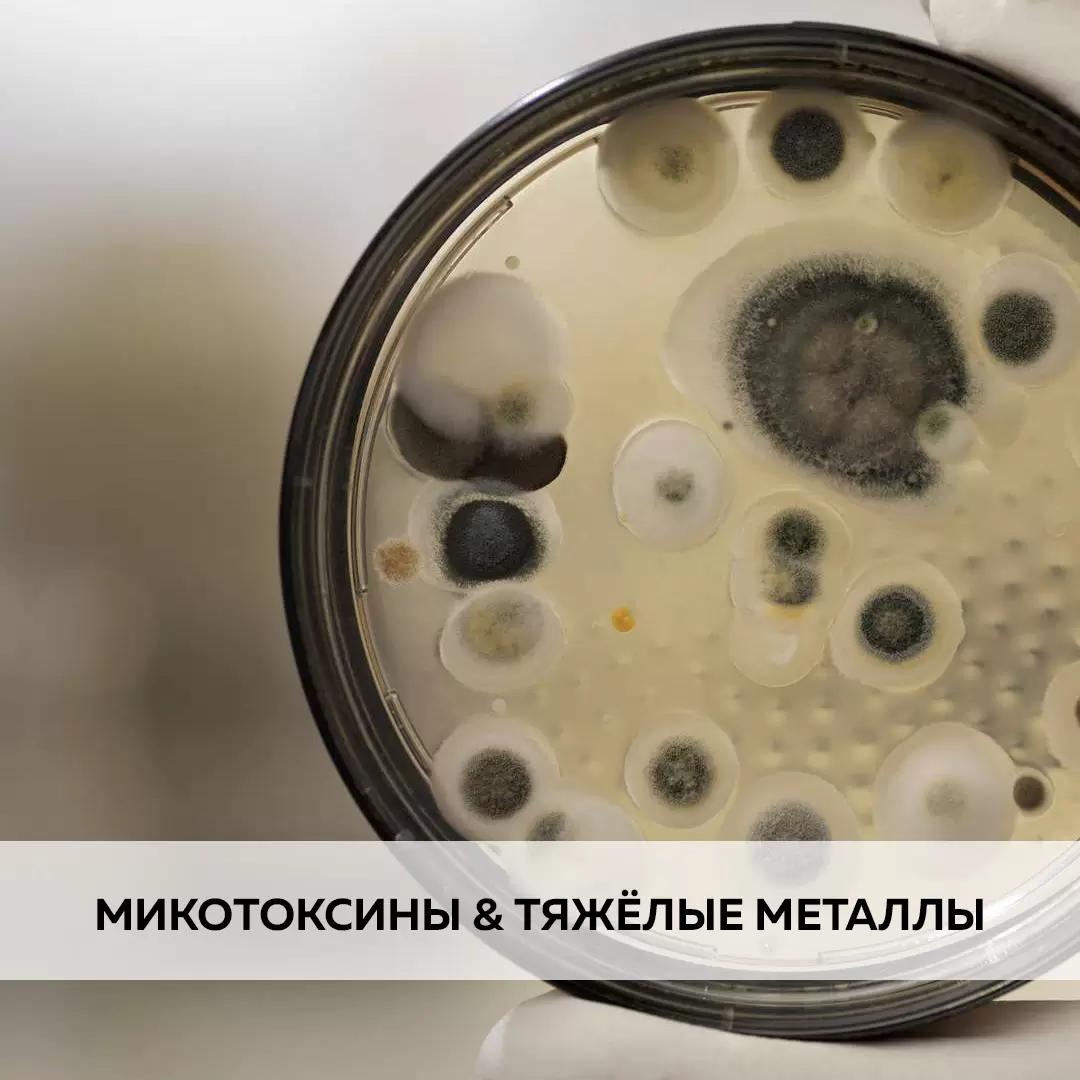
Микотоксины & Тяжёлые металлы

Микотоксины & Тяжёлые металлы
219
Одними из наиболее опасных токсических веществ в кормах животных являются микотоксины и тяжелые металлы.
Микотоксины — это вторичные метаболиты грибов, которые могут снижать питательную ценность кормов и оказывать токсическое воздействие на животных. Наиболее распространенные типы микотоксинов включают афлатоксины, зеараленон, фумонизины и тремор.
Это вещества, которые могут вызывать серьезные заболевания у животных, включая:
Заболевания молочной железы, бесплодие.
Снижение иммунитета, что приводит к повышенной восприимчивости к инфекциям.
Гепатоз и другие заболевания печени.
Тяжелые металлы, такие как свинец, ртуть и мышьяк, также представляют серьезную угрозу. Они могут попадать в рацион животных из загрязненных водоемов, почвы и кормов.
Влияние тяжелых металлов на здоровье животных может проявляться в виде:
Нарушения обмена веществ.
Нарушения функции почек и печени.
Онкологических заболеваний.
Чтобы минимизировать последствия воздействия микотоксинов и тяжелых металлов на здоровье животных в сельском хозяйстве применяют адсорбенты.
Микотоксины — это вторичные метаболиты грибов, которые могут снижать питательную ценность кормов и оказывать токсическое воздействие на животных. Наиболее распространенные типы микотоксинов включают афлатоксины, зеараленон, фумонизины и тремор.
Это вещества, которые могут вызывать серьезные заболевания у животных, включая:
Заболевания молочной железы, бесплодие.
Снижение иммунитета, что приводит к повышенной восприимчивости к инфекциям.
Гепатоз и другие заболевания печени.
Тяжелые металлы, такие как свинец, ртуть и мышьяк, также представляют серьезную угрозу. Они могут попадать в рацион животных из загрязненных водоемов, почвы и кормов.
Влияние тяжелых металлов на здоровье животных может проявляться в виде:
Нарушения обмена веществ.
Нарушения функции почек и печени.
Онкологических заболеваний.
Чтобы минимизировать последствия воздействия микотоксинов и тяжелых металлов на здоровье животных в сельском хозяйстве применяют адсорбенты.
Опубликовано: 02 октября, 2024 в 13:01
Похожие посты

Алкалоиды спорыньи: каков безопасный уровень для мясного КРС?

💡 Как выбрать адсорбенты для сельскохозяйственных животных?

♻ Механизм действия адсорбентов: как работают адсорбенты

Использование глины в качестве адсорбента
Типы адсорбентов


Нет комментариев